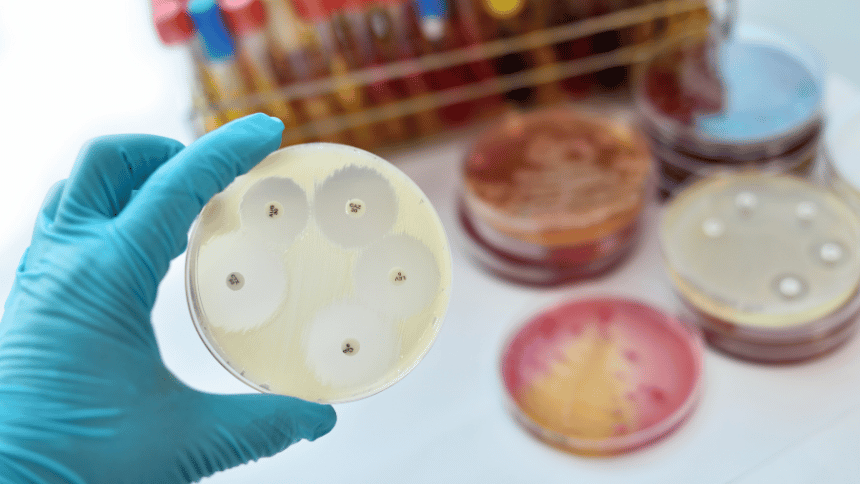
Antimikrobiální vlastnosti.

Proč není dobré hned sáhnout po antibiotikách z lékárny?
Zvyšování rezistence bakterií
Nadměrné nebo nesprávné používání antibiotik, zvyšuje riziko vzniku antimikrobiální rezistence. To znamená, že si bakterie a houby vybudují schopnost přežít i léčbu silnými léky. Takto rezistentní infekce se pak stávají obtížně léčitelnými a vyžadují dlouhodobější hospitalizace, nákladnější a toxičtější alternativy a ohrožují nejen běžnou léčbu, ale i moderní medicínu, od transplantací přes onkologii až po péči o chronicky nemocné.
Antibiotika jen na bakteriální infekce
Antibiotika jsou určena výhradně k léčbě bakteriálních infekcí, jako je streptokoková angína, dávivý kašel nebo infekce močových cest. Jsou nefunkční proti virovým onemocněním, a proto nepomohou při klasickém nachlazení, chřipce či většině případů bronchitidy. I některé bakteriální infekce, například mírný zánět dutin, lze zvládnout bez antibiotik a lze využít ze široké nabídky, kterou nabízejí přírodní antibiotika na záněty a lze je podle homeopatických pravidel kombinovat s klasickou léčbou.
Kdy má smysl zkusit přírodní alternativy
U lehkých a začínajících infekcí
V tomto případě lze sáhnout po přírodních zdrojích s antibakteriálními a protiplísňovými účinky. Sem se řadí například česnek, med, zázvor, oregano či tymián. Dále lze jako přírodní antibiotika využít olej z čajovníku nebo hřebíček, jejichž účinek je doložen jak tradičně, tak i vědecky.
Jako doplněk k léčbě
Pro tento účel lze využít například extrakt z brusinek, který je ceněn pro své antibakteriální a antioxidační účinky, zejména při problémech s močovými cestami.
Při rekonvalescenci nebo jako prevence opakujících se zánětů
Výzkumy ukazují, že některé byliny a přírodní látky mohou mít podobný efekt jako chemicky produkovaná léčiva, proto se mnohdy využívají při rekonvalescenci nebo jako prevence, aniž by se budovala rezistence.

Jak příroda bojuje s bakteriemi
Původ účinných látek v klasických antibiotikách
Aktinobakterie produkují významné látky, jako je streptomycin či tetracykliny, zatímco houby rodu Penicillium a Cephalosporium stojí za objevem penicilinu a cefalosporinů. Rostliny ke své obraně využívají sloučeniny, jako jsou fenoly, terpenoidy a alkaloidy, které lze využít jako přírodní antibiotikum. Moderní výzkum přinesl objev syntetických látek, jako jsou sulfonamidy a chinolony, které potvrdily, že účinná antibiotika mohou vznikat i mimo přírodní zdroje.
Vlastní antibakteriální látky hub a bylin
Vedle klasických antibiotik tu jsou i některé bylinky, esenciální oleje či potraviny, které dokážou zpomalit růst bakterií. Typickým příkladem je česnek, nebo med.
Nejznámější přírodní antibiotika
Česnek
Allicin a jeho silný antibakteriální, antivirový i antimykotický účinek
Česnek je známý jako jedno z nejsilnějších přírodních antibiotik mezi bylinkami. Obsahuje látky jako allicin, ajoen a allylsulfid, které vykazují silné antibakteriální, antivirové i antimykotické vlastnosti.
Role česneku při nachlazení, chřipce, při bolestech i proti plísním
Studie ukazují, že česnek může pomoci při nachlazení, ale i při boji s plísněmi a některými bakteriemi, jako jsou Klebsiella pneumoniae, E. coli či Staphylococcus aureus.
Cibule
Protizánětlivý a baktericidní účinky quercetinu a allicinu
Cibule dokáže bojovat proti bakteriím, jako jsou E. coli, Pseudomonas aeruginosa, Bacillus cereus či Staphylococcus aureus, a výzkumy potvrzují její vliv i na Helicobacter pylori, který souvisí se vznikem žaludečních vředů. Quercetin navíc dokáže poškodit buněčné stěny patogenů.
Pomoc cibule při nachlazení a respiračních onemocněních
Cibule obsahuje kvercetin, který pomáhá mírnit záněty a tím podporuje imunitní systém. Důležitý je i selen, jenž taktéž pomáhá se zánětem a aktivuje obranné reakce organismu. Díky rozpustné vláknině cibule podporuje zdravý střevní mikrobiom, od kterého se odvíjí velká část imunity.
Cibulová šťáva a její využití
Pokud chcete čerpat, co nejvíce z benefitů cibule, dejte přednost její konzumaci než pití. Do vody se totiž neuvolní dostatek cenného quercetinu ani vlákniny, která je zásadní pro zdraví střevní mikrobioty a tím i imunitního systému.
Recept na cibulový sirup s medem
Raději, než cibulovou vodu si dopřejte cibulový sirup s medem. Cibuli stačí nakrájet, zalít tekutým medem a nechat několik hodin až dní louhovat. Poté sirup přecedíte a skladujete v lednici.

Dobromysl (oregano)
Antimikrobiální a protizánětlivé účinky silic thymol a karvakol
Oregano je vyhledávané pro své výrazné antimikrobiální a protizánětlivé účinky, které mu dodávají silice thymol a karvakrol. Tyto benefity jsou podpořeny i výzkumy, jenž ukazují, že olej z oregana může působit jako přírodní bylinné antibiotikum, zejména díky karvakrolu. Účinný je například proti bakteriím Streptococcus mutans, jež způsobují zubní kazy.
Čaj z dobromyslu pro celkové posílení imunity
Lžíci sušené bylinky stačí zalít vroucí vodou a louhovat asi čtyři minuty a dochutit ho oblíbeným sladidlem.
Echinacea (třapatka)
Antibakteriální a antivirotický účinek kořene třapatky
Tato bylinka patří k těm nejznámějším rostlinám, které se po staletí využívají pro posílení obranyschopnosti a léčbu infekcí. Extrakty z jejího kořene mají antibakteriální i antivirotické účinky, a proto bývá označována jako přírodní antibiotikum.. Tradičně se používala k hojení ran či při infekcích močových cest a výzkumy ukazují, že může působit i proti bakteriím spojeným s respiračními onemocněními.
Křen
Vlastnosti enzymu lysozom
Lysosomy obsahují enzymy, které dokážou rozložit látky, jako jsou bakterie nebo jiné částice, a také vlastní buněčné složky, pokud je nutné je zničit. Tyto enzymy nejlépe pracují v kyselém prostředí.
Využití křenu při rýmě, angíně, zánětu dutin i při obnově střev po léčbě antibiotiky
Křen obsahuje sloučeninu sinigrin, která dokáže mírnit zánětlivé procesy v těle a podporovat zdraví srdce. Díky isothiokyanátům navíc působí jako přírodní antibiotikum na záněty, protože dokáže ničit bakterie, jako je E. coli, Salmonela nebo H. pylori, a také zastavovat růst plísní, jež způsobují nepříjemné infekce kůže a nehtů.

Zázvor
Komplexní působení na viry, bakterie i plísně
Tento kořen dokáže komplexně působit na viry, bakterie i plísně. Obsahuje sloučeniny, které brání množení různých mikroorganismů včetně bakterií způsobujících parodontální onemocnění, E. coli či stafylokokových infekcí.
Zázračná kombinace gingerolu a zázvorových silic
Tato kombinace se ukazuje jako silné přírodní atb – gingeroly působí antioxidačně a protizánětlivě, zatímco zázvorové silice mají antiartritické účinky.
Recept na zázvorovo-medový sirup
Ve středně velkém hrnci smíchejte med, vodu a zázvor, přiveďte k varu a míchejte, dokud se med nerozpustí. Poté hrnec odstavte, nechte sirup 30 minut až jeden den louhovat, nakonec zázvor sceďte.
Tea Tree olej
Jak používat olej z čajovníku
Olej z čajovníku je využívaný pro své antimikrobiální, protiplísňové i antivirové účinky. Nikdy by se ovšem neměl aplikovat neředěný přímo na pokožku. Pro bezpečné použití je nutné jej smíchat s nosným olejem, například kokosovým či mandlovým, v poměru 1–2 kapky Tea Tree oleje na 12 kapek nosného oleje.
Brusinky
Extrakt z brusinek pomáhá při zánětech močových cest
Významný účinek spočívá ve sloučeninách, které brání bakteriím usazovat se na stěnách močových cest. Podle rozsáhlé analýzy, která zahrnovala více než 3000 účastníků z celého světa, dokáže brusinková šťáva snížit riziko vzniku infekcí močových cest až o 54 %. Výzkum také ukázal, že brusinky snižují potřebu použití antibiotik o 59 % a zmírňují projevy již probíhající infekce.

Hřebíček
Antibakteriální a analgetické vlastnosti eugenolu
Léčivé vlastnosti hřebíčku spočívají v obsahu eugenolu, který působí antibakteriálně i analgeticky. Studie potvrdily, že je účinný proti nebezpečným bakteriím, jako jsou S. aureus a E. coli.
Recept na hřebíčkový sirup s medem a skořicí
Na přípravu hřebíčkového nápoje smíchejte ¼ lžičky hřebíčkového prášku, 1 lžičku skořice a ½ lžičky mletého zázvoru, přidejte šťávu z půlky citronu a zalijte šálkem horké vody. Přikryjte a nechte 30 minut louhovat, poté sceďte a vmíchejte 1 lžíci medu.
Lichořeřišnice
Využití lichořeřišnice při opakovaných zánětech
Lichořeřišnice se nejčastěji využívá v boji proti opakovaným zánětům, protože podporuje silnou protizánětlivou reakci organismu.
Lichořeřišnice ve formě kapek i tinktury
Studie ukazují, že kapky nebo tinktura z lichořeřišnice dokážou zvýšit aktivitu antioxidačních enzymů, čímž chrání buňky před oxidačním stresem a poškozením DNA. V tradiční medicíně se používá k léčbě bronchitidy, zubních bolestí, vysokého cholesterolu i hypertenze.
Rakytník
Vysoký obsah vitamínu C a ochrana střevní mikroflóry
Rakytník se řadí mezi tzv. superpotraviny, protože obsahuje velké množství vitamínu C a více než 190 aktivních biosloučenin v semenech, plodech a šťávě. Dále obsahuje vitamíny A, B, K a E, minerály jako železo, vápník, hořčík či zinek, polyfenoly a flavonoidy (např. kvercetin a kaempferol) a vzácné mastné kyseliny omega 3, 6, 7 a 9. Některé studie naznačují, že rakytník může pomoci snižovat záněty gastrointestinálního traktu a podporovat hojení žaludečních vředů.
Využití rakytníkového oleje
Rakytníkový olej podporuje krevní oběh a zpomaluje projevy stárnutí. Díky rostlinným sterolům, jako je beta-sitosterol a kampesterol, hydratuje pokožku, vyhlazuje její texturu a zvyšuje elasticitu.

Med a propolis
Při léčbě nachlazení, infekcí horních cest dýchacích a chřipky
Med se řadí k silným přírodním antibiotikům. Disponuje antibakteriálními účinky, podporuje hojení ran, hydratuje poškozenou kůži a sliznice a obsahuje vitamíny, minerály a bílkoviny.
Výjimečnost manukového medu
Manukový med navíc obsahuje leptosperin, flavonoidy a fenolové kyseliny, které zvyšují jeho protizánětlivé a antioxidační účinky.
Silný protizánětlivý a imunomodulační účinek propolisu
Propolis, pryskyřičná směs sbíraná včelami, podporuje imunitu, působí antibakteriálně, protiplísňově a protizánětlivě a zároveň zklidňuje podrážděné sliznice.
Čaj Lapacho
Pomoc při začínajícím nachlazení a zánětech
Lapacho obsahuje beta-lapachon, který bojuje proti bakteriím a plísním, snižuje oxidační stres a chrání mozkové buňky. Jeho pozitivní účinky jsou podpořeny i výzkumem, který ukazuje, že může být prospěšný při léčbě artritidy, astmatu nebo zánětlivých onemocnění střev.
Při horečce se Lapacho nedoporučuje
Aktivní látky v lapacho mohou zvyšovat metabolickou zátěž a dráždit žaludek, což může oslabený organismus ještě více zatížit.
Chlorella
Chlorellin a jeho silný detoxikační a antibiotický účinek
Aktivní látka chlorellin a antioxidanty violaxanthin a lykopen snižují záněty, podporují obranyschopnost organismu a zlepšují celkovou regeneraci organismu.

Léčivé houby
Betaglukan jako prevence nachlazení a chřipek
Beta-glukan je přírodní polysacharid obsažený v buněčných stěnách hub, kvasinek a obilovin, jako je oves či ječmen. Studie ukazují, že dokáže přeprogramovat imunitní buňky a zabránit nadměrnému zánětu, který je často příčinou komplikací u chřipky. Beta-glukan zároveň chrání plíce před poškozením souvisejícím s virovými infekcemi a zvyšuje imunitní odolnost.
Antimikrobiální aktivitu vykazuje 75 % hub
Zhruba 75 % z polyporové hub vykazuje silnou antimikrobiální aktivitu a mnohé z nich mají také antivirové, cytotoxické nebo antineoplastické vlastnosti.
První antibiotikum: Penicilin
Za objeven prvních antibiotik stojí plíseň Penicillium. Po jeho izolaci a čisté výrobě v roce 1942 se penicilin stal prvním široce používaným antibiotikem přírodního původu a položil základy moderní antibiotické léčby.
Houby jako adaptogeny
Adaptogenní houby pomáhají tělu snižovat negativní účinky fyzického, biologického a chemického stresu. Regulují uvolňování glukokortikoidů včetně kortizolu a podporují regeneraci a homeostázu organismu.
Houby nesmrtelnosti podle tradiční čínské medicíny
Reishi (lesklokorka)
Reishi podporuje funkci nadledvin a pomáhá tělu reagovat na stres, chrání mozek před stresem a zlepšuje paměť.
Shiitake (houževnatec)
Shiitake jsou nejvíce dostupnými adaptogeními houbami v obchodech, bohaté na vitamín D, zinek a vitamíny skupiny B, podporují imunitu a kardiovaskulární zdraví.
Cordyceps (housenice)
Cordyceps snižuje účinky fyzického stresu a ve studiích zlepšoval adaptaci sportovců na vysokou nadmořskou výšku a únavu.
Hlíva ústřičná
Hlíva ústřičná obsahuje antioxidanty a může pomáhat regulovat hladinu cukru v krvi, snižovat cholesterol a podporovat imunitní systém.

Kdy přírodní antibiotika nestačí
Při vysoké horečce trvající déle než 3 dny
Pokud se vedle horečky objeví příznaky jako je třes a zimnice, může jít o závažnější bakteriální infekce, a tedy antibiotická léčba bude nezbytná.
Pokud se stav nebo bolest zhoršuje
Virové infekce mohou být komplikovány sekundární bakteriálními infekcemi, například zánětem dutin nebo pneumonií. Je proto důležité příznaky bedlivě sledovat a popřípadě konzultovat s lékařem zařazení antibiotik.
Jestliže existuje podezření na zánět ledvin, sepsi nebo jinou závažnou infekci
Při závažnějších infekcích, jako je infekce krevního oběhu, bakteriální pneumonie, streptokoková faryngitida nebo infekce močových cest, je nutný zásah odborníka, který nasadí cílenou léčbu antibiotiky.


